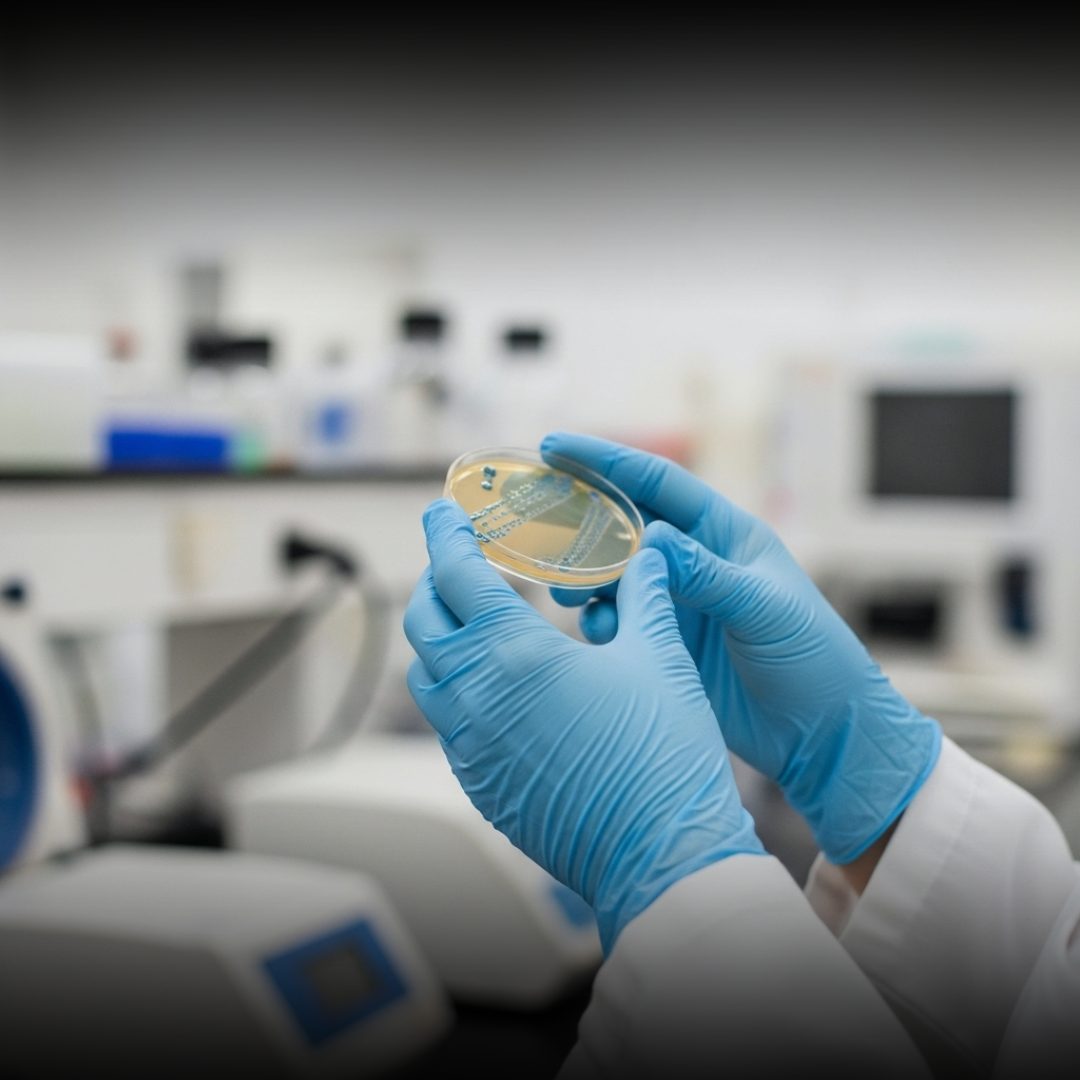

You can build calm, steady health with vegan vitamin B12 supplements. You are not failing if you need support, you are simply listening to your body. A vegan lifestyle can feel light and intentional. It can also raise simple nutrition questions. Vitamin B12 is one of the big ones. You deserve clear guidance that does not overwhelm you. You also deserve choices that fit your values. That is mindful nourishment.
This guide walks with you, step by step. You will learn about vitamin B12, food options, and smart supplement habits. You will also learn when to ask for help. Take a slow breath before you start. Your path can be practical and kind. Your health can be steady and whole.
Why vitamin B12 matters for your everyday strength

Vitamin B12 supports healthy red blood cells and steady energy. It also supports your brain and your nerves. Your nervous system relies on it. Vitamin B12 helps your body make DNA synthesis happen. It also supports cell division and repair. That matters for growth and recovery. When vitamin B12 runs low, blood cells can change shape. That can affect oxygen delivery and stamina. You may notice lower energy levels.
Vitamin B12 also supports healthy nerve cells. It helps protect nerve coverings and signal flow. That is part of your nervous system. You can think of vitamin B12 as a quiet builder. It supports blood cells, nerves, and mental clarity. It fits into a wider set of vitamins.
Check out this Nutricost Vitamin B12 here.
Why vegan and vegetarian patterns need special B12 care

Vitamin B12 is found naturally in many animal foods. That includes meat, eggs, and dairy products. Plant foods usually do not provide enough. This is why a vegan diet needs a plan. It is also why a vegetarian diet needs attention. Both patterns can be balanced and strong. A vegan or vegetarian diet can still meet essential nutrients well. You just need a reliable source for vitamin B12. That is a normal step.
Some people assume they can “eat clean” and avoid supplements. Yet vitamin B12 is different from many other nutrients. It is not made by plants. When you embrace a plant-based diet, you choose intention. Your body still needs vitamins to run smoothly. Vitamin B12 is one of them.
Fortified foods and smart food planning without pressure

Fortified foods can support your vitamin B12 intake. Common options include fortified cereals and fortified plant milks. Some nutritional yeast is fortified too. Food choices matter, but they do not need to be perfect. You can build a steady base with plant-based meals. Then you can add smart backups.
Look for labels that list vitamin B12 per serving. That is your easiest check. It turns food planning into a simple habit. Nutritional yeast can add a cheesy taste to food. Some brands provide vitamin B12 through fortification. Use it as flavor, not a sole plan. Plant foods still matter for other nutrients and fiber. Think legumes, leafy greens, and whole grains. Add tree nuts when you want crunch.
Check out this NuTrail Nut Granola Cereal here.
Supplements as a calm safety net, not a moral test

Supplements can be a steady support tool. They are not a sign of weakness. They are a practical part of health. Many vegans use dietary supplements for vitamin B12. Many vegetarians do too. This is common in real life. Dietary supplements can fill gaps in food patterns. They can also help when schedules get busy. You stay consistent without stress.
A vegan supplement can be simple and affordable. You can choose chewables, sprays, or tablets. Pick what you will actually use. When you use vegan vitamin B12 supplements, you support your long game. You build security for blood cells and nerves. You also protect energy levels.
Check out this NATURELO Vegan B12 here.
Understanding forms, active forms, and what labels really mean

Vitamin B12 supplements come in various forms. Cyanocobalamin is common. Methylcobalamin is also common. Methylcobalamin and adenosylcobalamin are active forms in the body. Some labels highlight this detail. The bigger goal is consistent intake. Other forms include hydroxocobalamin in some settings. You may also see “other forms” listed on labels. Do not let that confuse you.
A B complex may include vitamin B12 with other B vitamins. It can support broad coverage. It can also overlap with many supplements. You can keep it simple. Choose a product with clear dosing and third-party testing. That is a key sign of high-quality supplements.
Check out this Bronson Vitamin B12 here.
Absorption, intrinsic factor, and why your gut matters

Your body needs intrinsic factor to absorb vitamin B12 well. This protein helps vitamin B12 move through digestion. Absorption can change with age. Some people have absorption issues that reduce vitamin B12 uptake. Pernicious anemia is one cause. It can reduce intrinsic factor production. Certain conditions can also reduce absorption. Crohn's disease can affect the ileum. Celiac disease can also change absorption in some people.
Some gastric acid inhibitors can reduce vitamin B12 release from food. These include long-term acid-lowering medicines. Certain medications can add risk. If you use gastric acid inhibitors or metformin, talk with a healthcare professional. You may need testing or a different plan. Your body deserves clarity.
Signs to notice and why early action protects you

Vitamin B12 deficiency can show up slowly. You may notice fatigue, low mood, or brain fog. You may also notice tingling. Some symptoms can include muscle weakness or balance changes. In severe cases, nerve damage can happen. That is why steady habits matter. Healthy red blood cells support oxygen delivery. When blood cells are not healthy, you can feel tired. You may also feel short of breath.
Older adults can face a greater risk of low vitamin B12. Absorption often falls with age. This can happen even with animal products. Pregnant women also need careful B12 support. Vitamin B12 supports growth and cell division. A registered dietitian can guide you gently.
Dosing basics, higher doses, and a simple weekly routine

You may see different dose styles on supplement labels. Some people use a tablet daily. Other plans use higher doses less often. Higher doses can help because absorption is limited each time. This is normal biology. It does not mean you are doing something wrong. A common approach is to take a tablet daily for steady habit building. Another approach uses higher doses weekly. Your needs can differ.
If you struggle to swallow pills, choose a chewable or liquid. Many supplements offer these options. Comfort supports consistency. If you are unsure, start with a simple routine. Keep your vitamin B12 supplement near breakfast food. Pair it with a calm moment.
How to choose vegan vitamin B12 supplements you can trust

Start with reliable source signals. Look for third-party testing and clear labels. Avoid vague “proprietary blends.” Choose vegan vitamin B12 supplements that fit your lifestyle. Consider non gmo and gluten-free options if needed. Keep ingredients short. Check for allergens and additives that do not serve you. If you have celiac disease, gluten-free labeling matters. Your body deserves safety.
Be mindful of taking many supplements at once. Too many overlapping vitamins can create confusion. A B complex may already cover B vitamins. If you want support, ask health professionals for guidance. A registered dietitian can review your food pattern. They can also check supplement overlap.
Vegan diet quality beyond B12, with other nutrients in mind

A vegan diet supports health when it is varied. Build meals with whole food basics. Use plant-based proteins, grains, and vegetables. Focus on other nutrients too. Iron, iodine, zinc, and omega fats matter. Vitamin D also supports long-term health.
Vitamin D can be low in many people. Some vegans use supplements for vitamin D. You can treat this as mindful support. Do not fear food variety. Include legumes, seeds, and tree nuts. Rotate plant foods to cover nutrients. Your plant-based diet can be both joyful and structured. It can include fortified foods and supplements. That is modern, not flawed.
READ ALSO: Best Vitamin D Supplement, Backed by Science
Vegetarian choices, animal products, and common real-life transitions

Some people move from vegan to vegetarian. Others move from vegetarian to vegan. Both paths can still be mindful. Vegetarian patterns may include dairy products and eggs. Yet vitamin B12 intake can still be low sometimes. It depends on food choices. Meat eaters often get vitamin B12 from meat and dairy. Still, some meat eaters develop low levels due to absorption. Age and meds matter.
You do not need to judge meat consumption to care for your body. You can respect your values and your needs, you can also learn from research. If you include animal products, keep them intentional. If you do not, plan for fortified foods and supplements. Your goal is steady vitamins.
Safety, side notes, and what “generally considered safe” means

Vitamin B12 is generally considered safe for most people. It is water-soluble, and excess is often excreted. Still, dosage choices should be thoughtful. Some people worry about cancer risk with vitamins. The research is complex, and not one size fits all. Focus on meeting needs, not mega dosing.
If you use certain medications, ask about interactions. This matters with gastric acid inhibitors and metformin. It can also matter after surgery. Do not self-diagnose with random symptoms. Many symptoms overlap across conditions. Use testing to get clear answers. If you are managing a condition, talk with a healthcare professional. This is especially true for older adults and pregnant women. Support is strength.
Testing, biomarkers, and working with the National Institutes of Health guidance
Vitamin B12 status can be checked with blood tests. Some tests look at serum B12. Others look at related markers. Health professionals may also check methylmalonic acid or homocysteine. These can add context. Your goal is clarity, not fear. You can use National Institutes of Health resources as a reliable source. Their Office of Dietary Supplements shares evidence-based guidance. This is a calm starting point.
When you read online, filter for quality. Look for professional organizations and national institutes. Avoid hype and extreme claims. If you want a plan, ask a registered dietitian. They can match supplements, food patterns, and lab needs. That can reduce overwhelm fast.
READ ALSO: Consolidated Health Plan: Gentle Guidance for Smart Choices
The bigger picture of B vitamins, B complex, and energy support

Vitamin B12 works with other B vitamins. These B vitamins support energy metabolism. They also support blood and nerve health. A B complex can cover several B vitamins together. It may include folic acid and other nutrients. It can be helpful for some people. Folic acid supports healthy blood cells too. It works alongside vitamin B12 in cell building. Balanced intake matters.
You do not need to chase every new supplement. Choose essentials, then stay steady. Most health benefits come from consistency. When energy levels dip, check basics first. Sleep, food, hydration, and stress matter. Supplements support, but they do not replace body care.
READ ALSO: Vitamin B1 Supplement With Whole-Body Benefits
Mindful nourishment, research notes, and your next calm step

Research on plant-based patterns keeps growing. A review led by Bakaloudi, Dr., highlights common vitamin B12 gaps in vegan groups. This supports planning, not panic. Plant-based living can help mitigate cardiovascular disease risk factors through the consumption of fiber-rich foods and high-quality foods. Yet you still need vitamin B12 for blood cells. Both truths can sit together. Keep one simple goal. Use fortified foods and supplements as your steady net. Treat vitamin B12 as daily care.
If you want a gentle routine, pick one product and stick to it. Use a tablet daily or a weekly higher dose plan. Add reminders that feel kind. You are building a body that can carry your values. You are choosing health with intention. Your vitamins and supplements can support that journey.






